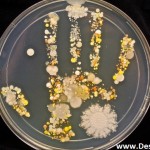

Η περίοδος των εξετάσεων είναι από τις πιο αγχωτικές στη ζωή ενός ανθρώπου, είτε πρόκειται για το σχολείο, είτε για το πανεπιστήμιο, αλλά και για κάθε άλλο σημαντικό τομέα. Όπως και να έχει, πολύ μεγάλο ρόλο σε όλη αυτήν την προσπάθεια παίζει και η διατροφή, η οποία μπορεί να έχει τις καλύτερες επιδράσεις στον εξεταζόμενο, όταν είναι ισορροπημένη και με μέτρο.
Διαβάστε παρακάτω πώς μπορείτε να βοηθήσετε τον οργανισμό σας, παρέχοντάς του ενέργεια και πνευματική διαύγεια μέσα από το φαγητό, σε μια περίοδο πίεσης, που η ψυχοσωματική σας τόνωση είναι απαραίτητη.
Ξεκινήστε τη μέρα σας με ένα καλό πρωινό
Ένα ολοκληρωμένο πρωινό προσφέρει ενέργεια, καλή ψυχολογία και πνευματική διαύγεια, ενώ μειώνει την αίσθηση της πείνας κατά το μεσημέρι, με αποτέλεσμα να μειώνεται και η υπερκατανάλωση φαγητού αργότερα, γεγονός που αποτρέπει το αίσθημα υπνηλίας και τη χαμηλή απόδοση του εξεταζόμενου. Γαλακτοκομικά, αμυλούχες τροφές, ψωμί ή φρυγανιές, φρούτα και χυμοί είναι μερικές προτάσεις.
Προτιμήστε υγιεινά σνακ
Πολύ σημαντικά είναι και τα ενδιάμεσα γεύματα, που μειώνουν την πείνα και προσφέρουν περισσότερη ενέργεια την ώρα του διαβάσματος. Ιδανικές επιλογές για σνακ αποτελούν οι παρακάτω:
φρουτοσαλάτα με φρούτα, μέλι, κανέλα και ξηρούς καρπούς,
γιαούρτι με φρούτα, μέλι και ξηρούς καρπούς,
δημητριακά ολικής αλέσεως με ημιάπαχο γάλα,
μπάρα δημητριακών ολικής αλέσεως με φρούτα ή με σοκολάτα,
αποξηραμένα φρούτα ή 1 κομμάτι σοκολάτα υγείας ή παστέλι.
Μικρά και συχνά γεύματα
Η κατανάλωση μικρών και συχνών γευμάτων συμβάλλει στην εγρήγορση και στην καλή απόδοση του εξεταζόμενου, σε αντίθεση με τα μεγάλα γεύματα, που οδηγούν στην υπνηλία και αυξάνουν την ανικανότητα της σκέψης. Οπότε, μικρές ποσότητες ανά 2-3 ώρες και το αίσθημα της πείνας θα εξαφανιστεί, χωρίς να έρθει ο υπερκορεσμός.
Ισορροπημένη διατροφή
Όλες οι ομάδες τροφίμων, σε λογικές ποσότητες, είναι απαραίτητες, ενώ το χειρότερο κατά την περίοδο της προετοιμασίας ή των εξετάσεων είναι η άστατη διατροφή, οι λίγες ώρες ύπνου και ο πολύς καφές.
Ελαφρύ βραδινό πριν τη μεγάλη ημέρα
Ένα βαρύ βραδινό μπορεί να επηρεάσει αρνητικά τη χαλάρωση και την ξεκούραση του εξεταζόμενου και κατά συνέπεια την απόδοσή του την επόμενη ημέρα, ενώ επίσης, καλό θα ήταν να αποφευχθεί και η κατανάλωση καφέ ή άλλου ροφήματος με καφεΐνη το προηγούμενο βράδυ.
Την ημέρα των εξετάσεων
Απαραίτητο είναι ένα ελαφρύ και τονωτικό πρωινό, ώστε να δώσει ενέργεια στον οργανισμό, αλλά και να τονώσει τη μνήμη και τη συγκέντρωση.
Ο μύθος της καφεΐνης
Σε μικρές ποσότητες, ελαττώνει την αίσθηση της κόπωσης και προκαλεί εγρήγορση, όμως η κατανάλωσή της σε μεγάλη ποσότητα προκαλεί νευρικότητα, άγχος και αϋπνία, ειδικά για όσους δεν πίνουν συχνά ή καθόλου καφέ.